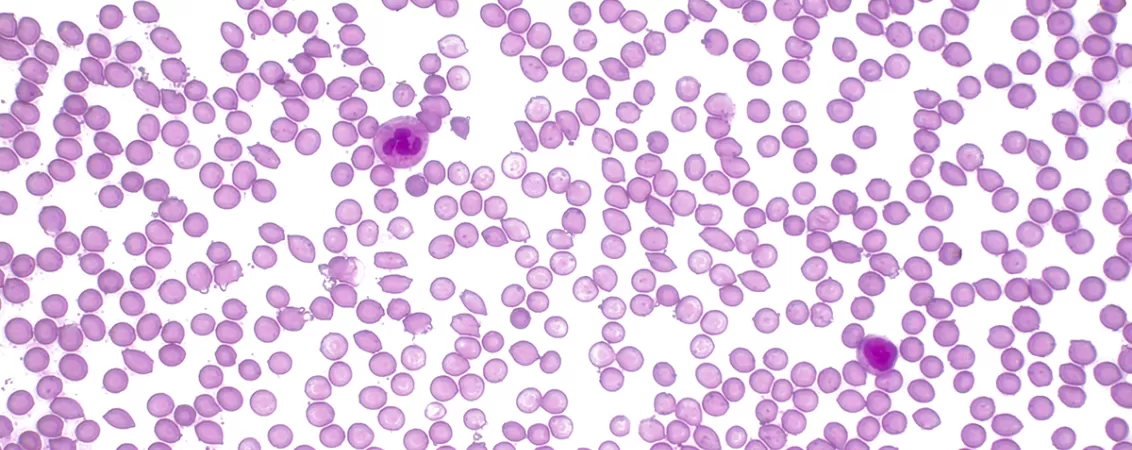

Hematii (globule roșii): ce sunt și ce rol au

Hematiile, cunoscute și sub denumirea de globule roșii, sunt celulele sanguine cele mai numeroase și joacă un rol esențial în transportul oxigenului la toate celulele corpului. Aceste celule au o structură unică, adaptată, care le permite să îndeplinească această funcție vitală, dar să transporte dioxidul de carbon înapoi la plămâni. În continuare, vom explora ce sunt hematiile, cum sunt produse, ce funcții au și cum modificările sau patologia lor pot afecta sănătatea organismului.
Ce sunt hematiile?
Hematiile sunt celule sanguine care joacă un rol crucial în menținerea funcțiilor vitale ale corpului. Aceste celule sunt caracterizate prin forma lor biconcavă, care le permite să capteze și să transporte eficient oxigenul. Spre deosebire de alte celule ale corpului, hematiile nu au nucleu, ceea ce le permite să aibă mai mult spațiu pentru hemoglobină, proteina responsabilă de transportul oxigenului. În sângele uman, hematiile sunt cele mai numeroase celule, iar în fiecare microlitru de sânge există aproximativ 5 milioane de hematii.
Hematiile sunt produse în măduva osoasă, un proces care se numește eritropoieză. Aceste celule au o durată de viață limitată, de aproximativ 120 de zile, iar atunci când devin vechi sau deteriorate, sunt eliminate din circulație de către splină și ficat. În această perioadă, ele îndeplinesc două funcții esențiale: transportul oxigenului de la plămâni la țesuturi și transportul dioxidului de carbon înapoi către plămâni pentru a fi eliminat din organism.
Deși sunt simple din punct de vedere structural, hematiile sunt foarte eficiente în realizarea sarcinilor lor. Datorită lipsei nucleului și structurii lor biconcave, hematiile sunt extrem de flexibile și pot călători prin cele mai înguste capilare, care sunt de până la un sfert din dimensiunea lor. Această flexibilitate este esențială pentru transportul eficient al gazelor respiratorii.
Hematiile sunt în mod constant produse și distruse într-un echilibru perfect în organism. Producția lor este reglată de hormonul eritropoietină, care este secretat în principal de rinichi în momentul în care nivelul de oxigen din sânge scade. Acest mecanism asigură că organismul are întotdeauna suficient oxigen pentru a susține funcțiile vitale.
Anatomia și structura hematiilor
Hematiile au o structură unică care le permite să îndeplinească funcțiile lor vitale de transport al gazelor respiratorii. Aceste celule sunt biconcave, ceea ce înseamnă că au o formă plată și adâncită la mijloc, similară unei farfurii. Această formă nu doar că le conferă o suprafață mai mare pentru a transporta oxigenul, dar le permite și să se deformeze ușor, facilitându-le trecerea prin capilare înguste. Forma biconcavă ajută și la creșterea eficienței schimburilor de gaze, prin creșterea suprafeței de contact cu oxigenul și dioxidul de carbon.
Hematiile sunt compuse în principal din apă și hemoglobină, o proteină complexă care se leagă de oxigen. Hemoglobina reprezintă aproximativ 33% din greutatea unui eritrocit și este esențială pentru transportul oxigenului în organism. De asemenea, hemoglobina are un rol și în transportul dioxidului de carbon, care este transportat în sânge sub formă de bicarbonat, dar o mică parte se leagă și de hemoglobină.
În ciuda faptului că hematiile sunt celule care nu au nucleu, ele îndeplinesc funcții vitale datorită prezenței hemoglobinei și a altor componente esențiale. Membrana celulară a hematiilor este flexibilă și alcătuită dintr-un strat dublu de fosfolipide, care conferă celulei o mare elasticitate. Aceasta elasticitate le permite hematiilor să se deformeze pentru a se adapta la dimensiunile capilarelor sanguine, care sunt adesea mai înguste decât diametrul lor.
Lipsite de nucleu, hematiile nu pot efectua procesele de sinteză proteică sau reproducere, ceea ce înseamnă că nu pot se auto-repara în caz de daune. De aceea, durata lor de viață este limitată, iar procesul de îmbătrânire le face vulnerabile la descompunere, lucru care se întâmplă în mod regulat în splină.
O altă caracteristică importantă a hematiilor este faptul că acestea nu conțin mitocondrii, organite celulare care produc energie. Acest lucru înseamnă că hematiile nu consumă oxigenul pe care îl transportă, maximizând astfel cantitatea de oxigen disponibilă pentru țesuturi.
Producția hematiilor (eritropoieza)
Eritropoieza este procesul prin care hematiile sunt produse în organism și are loc în măduva osoasă. Acest proces este reglat cu precizie de către mai mulți factori, inclusiv de nivelurile de oxigen din sânge și de hormonul eritropoietină. În mod normal, măduva osoasă produce aproximativ 2 milioane de hematii pe secundă pentru a înlocui cele care au ajuns la sfârșitul ciclului lor de viață de aproximativ 120 de zile.
Procesul de eritropoieză începe cu o celulă stem hematopoietică, care se diferențiază în mai multe stadii pentru a deveni un eritrocit matur. Aceste etape includ proeritroblaste, eritroblaste și reticulocite. Pe măsură ce celula progresează prin aceste stadii, volumul nuclear scade și cantitatea de hemoglobină crește, iar în cele din urmă, celula matură este eliberată în sânge.
Eritropoietina (EPO) este hormonul principal care stimulează producția de hematii. Acest hormon este produs de rinichi ca răspuns la scăderea nivelului de oxigen din sânge. Când organismul detectează o scădere a oxigenului, cum ar fi în cazurile de anemie sau de altitudine mare, rinichii secretă mai mult eritropoietină, care stimulează măduva osoasă să producă mai multe hematii.
Factorii nutriționali, cum ar fi fierul, vitamina B12 și acidul folic, sunt de asemenea esențiali în procesul de eritropoieză. Deficiențele în aceste substanțe pot duce la o producție ineficientă de hematii și pot contribui la dezvoltarea diferitelor tipuri de anemie.
De asemenea, procesul de eritropoieză este reglat de sistemul imunitar și de diverse semnale hormonale, iar perturbările acestor mecanisme pot duce la diverse afecțiuni ale globulelor roșii.
Funcțiile principale ale hematiilor
Hematiile au două funcții principale care sunt esențiale pentru supraviețuirea organismului: transportul oxigenului și al dioxidului de carbon. Transportul oxigenului este posibil datorită hemoglobinei, o proteină care se leagă de oxigen în plămâni și îl transportă la țesuturi. În celulele din țesuturi, oxigenul este eliberat și este folosit pentru diverse procese metabolice. Acest proces de schimb de gaze este esențial pentru producerea de energie și pentru menținerea funcțiilor vitale ale organismului.
Pe lângă transportul oxigenului, hematiile sunt implicate și în transportul dioxidului de carbon, un produs rezidual al metabolismului celular. Aproape 70% din dioxidul de carbon este transportat sub formă de bicarbonat în sânge, iar o parte mică se leagă direct de hemoglobină, formând carbaminohemoglobină.
În plus, hematiile contribuie la menținerea echilibrului acido-bazic al sângelui prin tamponarea nivelului de ioni de hidrogen. Acest mecanism ajută la prevenirea acidificării sângelui, care poate afecta grav funcționarea enzimelor și a altor componente celulare.
Hematiile joacă, de asemenea, un rol în reglarea vâscozității sângelui. Prin faptul că ocupă un volum semnificativ din sânge, ele influențează viscozitatea acestuia, ceea ce poate afecta circulația sângelui și presiunea arterială. Vâscozitatea sânge este importantă pentru menținerea unui flux sanguin adecvat prin vasele de sânge.
Durata de viață și distrugerea hematiilor
Hematiile au o durată de viață medie de aproximativ 120 de zile. În această perioadă, ele călătoresc prin întregul sistem circulator, îndeplinindu-și funcțiile de transport al gazelor respiratorii. Pe măsură ce hematiile îmbătrânesc, ele devin mai rigide și mai vulnerabile la daune. În plus, cu cât hematiile sunt expuse mai mult la stresul mecanic și chimic, cu atât devin mai susceptibile la descompunere.
Distrugerea hematiilor vechi are loc în principal în splină, un organ care joacă un rol crucial în procesul de filtrare al sângelui. Splina conține macrofage, care identifică și înghit hematiile deteriorate. În acest proces, hemoglobina este descompusă, iar componentele sale sunt reciclate. Fierul, care este o componentă importantă a hemoglobinei, este stocat în ficat și măduva osoasă pentru a fi utilizat în producția de noi hematii. Bilirubina, un alt produs al descompunerii hemoglobinei, este excretată prin ficat și eliminată din organism prin bilă.
Procesul de distrugere a hematiilor, cunoscut sub denumirea de hemoliză, este un fenomen continuu care asigură că organismul menține un număr constant de globule roșii. Atunci când acest proces este deranjat, pot apărea afecțiuni precum anemia hemolitică, în care hematiile sunt distruse prea rapid.

Tulburări și afecțiuni ale hematiilor
Tulburările hematiilor pot afecta grav sănătatea generală a unui individ. Cele mai comune afecțiuni care implică hematiile sunt anemia și policitemia. Anemia este o afecțiune în care numărul de hematii sau cantitatea de hemoglobină din sânge este insuficientă pentru a asigura o oxigenare adecvată a organismului. Aceasta poate fi cauzată de pierderi de sânge, carențe nutriționale, afecțiuni cronice sau de defecte genetice ale hematiilor.
Policitemia, pe de altă parte, este caracterizată printr-un număr prea mare de hematii, ceea ce poate duce la creșterea vâscozității sângelui și creșterea riscului de formare a cheagurilor. Există două forme de policitemie: primară, care este o boală a măduvei osoase, și secundară, care apare în urma unor afecțiuni care duc la scăderea oxigenării.
Hemoglobinopatiile, cum sunt anemia falciformă și talasemia, sunt tulburări genetice care afectează structura hemoglobinei și, prin urmare, funcția hematiilor. Aceste afecțiuni pot duce la distrugerea prematură a hematiilor și la simptome grave, inclusiv dureri și anemie cronică.
Hematiile sunt esențiale pentru funcționarea optimă a corpului uman, având rolul vital de a transporta oxigenul și dioxidul de carbon prin sânge. Structura lor specializată le permite să îndeplinească aceste funcții într-un mod eficient și adaptabil, iar procesele de producție și distrugere ale acestora sunt reglate cu precizie pentru a menține echilibrul în organism. Tulburările care afectează hematiile pot duce la afecțiuni grave, iar monitorizarea acestora este crucială pentru prevenirea și tratamentul diferitelor condiții hematologice.
Disclaimer: Informațiile din acest articol nu înlocuiesc consultul medical sau recomandările specialistului.
Bibliografie
- “4.4: Erythrocytes.” Biology LibreTexts, 4 July 2020, bio.libretexts.org/Courses/Lumen_Learning/Anatomy_and_Physiology_II_(Lumen)/04%3A_Module_2-_The_Cardiovascular_System-_Blood/4.04%3A_Erythrocytes, accesat la 14.05.2025;
- Barbalato, Laura, and Leela Sharath Pillarisetty. “Histology, Red Blood Cell.” National Library of Medicine, StatPearls Publishing, 14 Nov. 2022, www.ncbi.nlm.nih.gov/books/NBK539702/, accesat la 14.05.2025;
- Cleveland Clinic. “Red Blood Cells: Function & Role.” Cleveland Clinic, Cleveland Clinic, 8 Nov. 2021, my.clevelandclinic.org/health/body/21691-function-of-red-blood-cells, accesat la 14.05.2025;
- “Erythrocyte - an Overview | ScienceDirect Topics.” Www.sciencedirect.com, www.sciencedirect.com/topics/agricultural-and-biological-sciences/erythrocyte, accesat la 14.05.2025;
- National Cancer Institute. “NCI Dictionary of Cancer Terms.” National Cancer Institute, Cancer.gov, 2019, www.cancer.gov/publications/dictionaries/cancer-terms/def/erythrocyte, accesat la 14.05.2025.
Solicită o programare
Aici puteți să solicitați o programare pentru serviciile noastre de oriunde vă aflați, fără telefon și fără vizită în clinică.
Analizele cu bilet de trimitere în decontare cu Casa de Asigurări de Sănătate se recoltează doar în baza unei programări prealabile.
Articole din aceeași categorie

Clitoris: ce este și ce rol are în anatomia feminină
Înțelegerea corectă a anatomiei feminine este esențială pentru sănătatea, educația și bunăstarea generală a femeilor. De-a lungul timpului, clitorisul a fost un organ adesea ignorat sau greșit înțeles, atât în cultura populară, cât și în manualele de medicină. Acest material își propune să aducă lum...

Colon: rol, funcții și afecțiuni comune
Colonul joacă un rol esențial în sistemul digestiv, fiind responsabil de absorbția apei și formarea materiilor fecale. Deși adesea trecut cu vederea, colonul influențează semnificativ sănătatea generală, în special prin legătura sa cu microbiomul intestinal. Înțelegerea funcțiilor sale și a afecțiun...

Sânge: compoziție, rol, importanță pentru organism
Sângele este un lichid vital care circulă neîncetat prin corpul uman, asigurând transportul oxigenului, al substanțelor nutritive și al hormonilor către celule, dar și eliminarea produselor reziduale. Deși este adesea privit doar ca un simplu „vehicul” biologic, sângele joacă un rol fundamental în a...